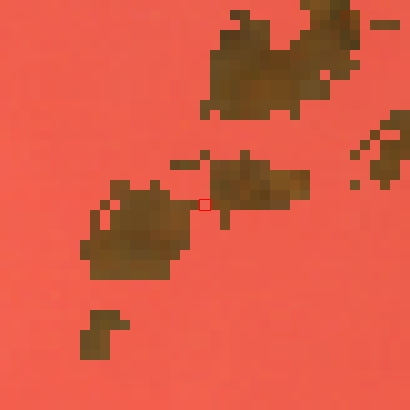

Jan/Feb
Mar/Apr
May/Jun
Jul/Aug
Sep/Oct
Nov/Dec
Jan/Feb
Mar/Apr
May/Jun
Jul/Aug
Sep/Oct
Nov/Dec
Sample 8966 Year 1995 |
|
Jan/Feb |
Mar/Apr |
May/Jun |
Jul/Aug |
Sep/Oct |
Nov/Dec | |
|
Jan/Feb |
Mar/Apr |
May/Jun |
Jul/Aug |
Sep/Oct |
Nov/Dec |
| 2021 |
|
MODIS |
| MODIS data |
| sixteen day composites |
|
|